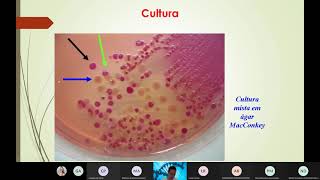

Microbiologia Médica: Introdução aos Bacilos Gram Negativos (Família Enterobacteriaceae)
42.13k views7180 WordsCopy TextShare

CS Ciências da Saúde
Microbiologia Médica: Introdução aos Bacilos Gram Negativos (Família Enterobacteriaceae)
Definição ...
Video Transcript:
o Olá pessoal tudo bem sejam bem-vindos mais uma vez ao canal Ciências da Saúde e esta é a primeira aula aqui na verdade essa aula Ela é uma introdução aos passivos gram-negativos muitos atirou canal me mandaram mensagens aqui nos comentários solicitando é uma da playlist almas sobre bacilos gram-negativos Então essa como eu falei a primeira aula na verdade é uma introdução eu acho que é muito importante antes de vocês assistirem qualquer outra aula e que eu irei colocar disponibilizar aqui no canal falando sobre aí espécies de bacilos gram-negativos assistir essa primeira aula que é uma
introdução hoje eu vou estar deixando algumas informações que são importantes no contexto é para entender na verdade né é sobre a importância de se estudar na verdade diferentes espécies ou seja diferentes tipos de bacilos gram-negativos então nessa aula eu vou falar mais esse ficar mente da família enterobacteriaceae se que é uma família é onde é apresenta diversos tipos nesse tem diversas espécies de bacilos gram-negativos bom então enterobacterias i é uma grande família de bacilos gram-negativos e comprados principalmente no intestino grosso de humanos é assim como em outras espécies de animais e muitos desses bacilos gram-negativos
são membros da nossa própria microbiota normal intestinal então esses organismos são os principalmente os principais na verdade perdão anaeróbios facultativos do intestino grosso então lá no nosso intestino grosso nós temos bactérias tanto é anaeróbias facultativas né ou seja bactérias que crescem tanto na presença quanto na ausência de oxigênio como também existem as anaeróbias que são obrigatórias claro que comparando aí nós temos muito mais e anaeróbias obrigatórias como por exemplo as paratireóides do que bactérias anaeróbias facultativas mas nessa aula poderei falar sobre espécies da família enterobacteriaceae se eu irei falar de espécies que são anaeróbias facultativas
é bactérias que podem causar infecções tanto intestinais como extra intestinais de importância Clínica certo A então embora sejam classificados Taxi completo taxonomicamente como um conjunto né gente fala família enterobacteriaceae ou também conhecido como enterobactérias né que são bactérias enterais a gente se refere como um conjunto porém essa família como já falei anteriormente apresenta uma grande quantidade né de gêneros ou seja de patógenos é e que pô o que fazem parte dessa família Essa é causa ou na verdade uma variedade de doenças e que essas doenças elas podem acontecer por diferentes mecanismos patogênicos A então cada
espécie que faz parte dessa família e ter uma criança e dependendo da espécie é você já dependendo do gênero tem o seu mecanismo de patogenicidade aí específico não é porque todas fazem parte de um amigo de uma mesma família de um mesmo grupo que apresentam o mesmo mecanismo patogênico espero que vocês tenham entendido nessa questão só aqui nessa primeira tabela nessa aula eu irei mostrar algumas tabelas com algumas informações que são importantes Aqui nós temos é doenças causadas por membros da família enterobacteriaceae' e Aqui nós temos os principais patógenos ou seja os principais micro-organismos a
a paz é bactérias né os eixos principais bacilos gram-negativos que são patogênicos estão aqui nós temos diferentes gêneros né o gênero scrik tigela salmonella crebiciela enterobacter serratia Proteus yersinia Então tudo isso daqui são gêneros né que são bactérias não são gêneros que possuem espécies patogênicas que fazem parte dessa família enterobacteriaceae' e aqui na frente nós temos as suas respectivas doenças né suas respectivas infecções como por exemplo escherichia Coli causa infecção do trato urinário causam diarreia do Viajante meningite Neonatal x ela causa desinteria salmonella febre tifoide enterocolite Aí temos aqui diferentes gêneros que causam tanto pneumonia
né enfim e como também infecções do trato urinário protheus causa infecções do trato urinário EA yersinia causa a famosa peste bubônica tenho certeza que todos vocês já ouviram falar entre o político e adenite mesentérica então Aqui nós temos diferentes gêneros e suas respectivas doenças né doenças mais representativas de cada um destes gêneros aqui que fazem parte dessa família enterobacteriaceae' e aqui do ladinho circulando nós temos outros gêneros que também são bacilos gram negativos relacionados né de menor importância Clínica tá então os bacilos gram-negativos que fazem parte dessa família ter uma criança de maior importância Clínica
São esses gêneros aqui né mas é importante lembrar que e os outros que podem também eventualmente causar infecções em seres humanos mas é normalmente causam doenças e outras espécies de animais que também são bacilos gram-negativos e aqui eu tenho algumas características né características gerais e importantes que essas características gerais elas são inerentes a essa a diferentes espécies as espécies na verdade net bacilos gram-negativos a como por exemplo são bactérias anaeróbias facultativas que o que eu já comentei inicialmente de no intestino grosso a gente tem bactérias que são anaeróbias facultativas e anaeróbias obrigatórias se você for
comparar obviamente lá no intestino grosso e nós temos muito mais anaeróbias obrigatórias do que facultativas mas as que são mais importantes para a medicina né ou seja bactérias que podem causar infecções são as anaeróbias facultativas são as mais estudadas tudo bem bom então além de serem anaeróbias facultativas essas espécies são catalase positivas ou seja são bactérias produtoras de enzima catalase são oxidase negativas com exceção da pseudomonas do gênero pseudomonas a em que é uma um gênero que possui espécies que são oxidados positivos é os bacilos gram-negativos né de modo geral tem uma característica importante com
relação à sua capacidade de obter energia que é de reduzir Nitrato em nitrito uma outra no outro detalhe importante que até então é isso é extremamente importante do processo de diagnóstico de identificação dos bacilos gram-negativos é que algumas espécies alguns gêneros são fermentadores de lactose Assim como e outros gêneros apresentam espécies que não são fermentadoras de lactose e Uma das uma das formas como a gente pode identificar como eu já falei isso é extremamente importante para o processo de diagnóstico de identificação de caracterização dessas diferentes espécies de bacilos gram-negativos é exatamente identificar Qual espécie que
ela pode positiva e quais que não são lactose que são lactose negativos né e uma das formas de como fazer as identificação é através de meios de culturas Como por exemplo o ar macuque que é o meio e que ele é tanto seletivo quanto diferencial existem outros exemplos de leite como o m e que é o meio e Usina azul de metileno que também tem essa característica é o meio tanto seletivo quanto diferencial eu coloquei com o exemplo Agar macconkey esse e-mail com relação a sua característica seletiva ele possui componentes na sua composição que inibe
o crescimento de wassily de bactérias gram-positivas permitindo apenas o crescimento de bacilos gram-negativos Então essa é uma característica né com relação a essa capacidade seletiva do ar uma Cook e a função diferencial a função diferencial está diretamente relacionada a essa a esse detalhe por citei anteriormente de que tem algumas espécies que são lactose positivas né você já fermentadores de lactose outras não então aqui de destacando né quais são lactose positivas e quais são negativas eu tenho aqui esse crica que eu disse ela e enterobacter serratia Então temos aqui quatro gêneros O que são gêneros que
possuem espécies de bactérias fermentadoras de lactose como que eu sei que essas espécies que pertence a esse gênero são fermentadoras de lactose quando elas crescem no agora uma conc elas adquirem uma coloração ou seja as suas colônias adquirem uma coloração Rosada né ou seja o mapa na tonalidade aí variando entre Rosa né que pode ser um rosa claro como um rosa mais escuro Então as colônias que adquirem essa coloração são a bactérias né fermentadoras de lactose no caso das bactérias que não são fermentadoras de lactose e como por exemplo x ela salmonella protheus Providência morganella
yersinia e seu domonas adquirem colônias incolores ou seja colônias explico Sagas a lei né Que ocorrerá a mudança na cor do Agar macconkey Agar macconkey original ele tem uma tonalidade rosada é o meio ele tem ele original Stereo ele tem uma cor rosa então quando ali naquela superfície cresce uma bactéria que é lactose negativa ou não fermentadoras de lactose além da colônia que cresce adquirir essa coloração é Esse aspecto incolor né a colônia ela fica incolor ou esbranquiçada o meio ele se torna Amarelo né então tem essa mudança de cor por uma questão também de
diferença de PH eu não vou entrar em mais detalhes o porquê dessa mudado com essa essa alteração de cor no meio assim como né que essas colônias elas adquirem essas diferentes cores e assim possibilitando a identificação se a fermentadora ou não mas aqui no canal tem uma aula é isso com mais detalhe que aula de classificação e caracterização dos meios de cultura é uma hora em que eu falo isso que exclusivamente sobre a maioria dos meios de cultura que são utilizados no setor de microbiologia então não deixe de assistir que isso é muito importante para
essa primeira identificação é com relação a essa capacidade da bactéria fermentar ou não à lactose que está presente no meio tudo bem e a esses vacilos ou seja os bacilos gram-negativos é que fazem parte dessa grande família enterobacteriaceae opção eu posso usar anaeróbios facultativos de maior importância Clínica podem ser subdivididos a subdivididos em três categorias clinicamente relevantes vamos começar focar um pouquinho mais é importante prestar atenção aqui que aqui é uma subdivisão né É em três categorias clinicamente relevantes tá Então qual que é essa primeira categoria é um seja essa na verdade essas categorias elas
estão relacionadas a fonte do sítio de infecção A então primeiro do trato intestinal então existem bacilos e existem enterobactérias gêneros nerd causam infecções do trato intestinal é assim como tem já outros gêneros né Assim como outras espécies que causam infecções do trato respiratório e fontes animais então nós temos aqui as três categorias clinicamente relevantes né trato intestinal trato respiratório e fontes animais tá pegando aqui apenas essa primeira categoria né trato intestinal a gente ainda pode é dividir Na verdade subdividir essa essa primeira categoria com patógenos ou seja gêneros o que causam infecções tanto internamente como
externamente como por exemplo aqui né vai ficar mais fácil de entender o gênero esqueriquia principal representante a espécie corre né então famosa esqueriquiacoli tão gênio explica e o gênero salmonella a esses dois gêneros causa infecções tanto intestinais como infecções Extra intestinais né então você pode tanto ter um quadro de diarreia desinteria causada por alguma espécie de esqui like a assim como de salmonella como você pode ter outros tipos de infecções que não acontecem né no trato intestinal tá tem gêneros que são principalmente internos ou seja né aqui como exemplo a gela vibrio campylobacter e helicobacter
Então temos aqui quatro gêneros que cada um desses gênios possuem aí diferentes espécies e que na maioria das vezes essas espécies causam infecções principalmente internas ou seja principalmente infecções intestinais E aí temos aqui outros gêneros que causam infecções somente externas Ou seja você não irá desenvolver uma infecção intestinal não terá o quadro de diarreia desinteria Mas você pode ter infecções de urina por exemplo pode ter uma sepse pode ter outras infecções fora do trato gastrointestinal porque são gêneros em que possuem espécies e causam infecções somente externas ou seja fora do trato intestinal como por exemplo
grupo Oi Cleide se ela enterobacter serratia então aqui clipe se ela e enterobacter serratia são três gêneros que formam aí um grupo chamado de grupo presencial e enterobacter serratia temos o grupo protheus Providência amor organela que também são outros três gêneros além de pseudomonas e bacteroides tá então aqui são diferentes gêneros agora com relação ao trato respiratório temos aqui o gênero haemofilus legionella e por de tela tá e fontes animais brucella Franciela pasteurella yersinia tão aqui no canal primeiramente eu pretendo postar vídeo aulas e que eu vou falar sobre cada uma espécie né é de
maior importância Clínica pertencentes a cada um desses gêneros aqui mas a inicialmente a gostar vídeo-aulas a focando mais nessa parte né em gêneros que causam infecções tanto intestinais quanto Extra intestinais ou seja gêneros que fazem parte dessa primeira categoria aqui que a categoria do trato intestinal tá ó E aqui nessa terceira tabela nós temos aqui é patógenos mais frequentes e menos frequentes seja Quais são aqueles que mais o indivíduo apresenta infecção intestinal assim como infecção urinária né É quais são aqueles menos frequentes né que com menor frequência indivíduo ele pode apresentar tanto infecção infecção intestinal
quanto extra-intestinal no caso quando a gente se refere a infecções Extra intestinais é na maioria das vezes a gente é tá se referindo a infecções do trato urinário porque no trato urinário que como a uma das principais formas da gente entrar em contato com bacilos gram-negativos é através de material fecal né porque a maioria dos bacilos gram-negativos de maior importância Clínica eles a colonização né eles que estão presentes no nosso intestino grosso alguns fazendo partes da parte da própria microbiota intestinal com outros não mas uma forma comum é através da eliminação das fezes e o
aparelho urinário é no caso a via urinária o canal da uretra é tanto masculino quanto feminino principalmente pensando na questão da mulher está muito próximo além da região anal então a acaba tendo infecções do trato urinário com maior facilidade Claro se você for comparar entre o homem EA mulher pensando nessa questão da própria anatomia né a mulher ela é muito mais suscetível a ter infecção urinária né bacteriana do que o homem por conta dessa proximidade Duda a região anal assim como também pelo tamanho do canal da uretra facilitando assim a chegada desse microrganismo e a
bexiga urinária tá então Aqui Nós Temos nessa tabela patógenos frequentes Epa tons menos frequentes né então eu coloquei aqui dois sítios de infecção né o trato intestinal e trato urinário então com relação ao trato intestinal ou seja que causa infecções intestinais as quais são os patógenos mais frequentes e os menos frequentes estão pensando aqui nos patógenos frequentes salmonella né que é responsável por causar a famosa salmonelose x ela causa shigelose né para infecção intestinal tambem e campylobacter que inclusive aqui no canal já postei uma aula falando sobre campylobacter né então salmonella shigella campylobacter são os
patógenos são exemplos de bacilos a causa infecções intestinais com maior frequência agora a patógenos que causam infecções intestinais com menos frequência esqueriquia vibrio e é a Sinhá A então nós temos aqui patógenos comendo até causar infecções intestinais comigo se frequência agora com relação ao trato urinário né com elas são ao trato urinário com mais frequência ou seja patógeno né que é frequentemente isolado né e amostras de urina principalmente em mulheres é o gênero esqueriquia a o gênio mês clica nós temos como principal representante a espécie cole é uma bactéria que nós temos tanto o homem
quanto a mulher independente em grande quantidade que faz parte da nossa própria microbiota intestinal e por conta dessa questão da proximidade né e a uretra da região anal no caso da mulher é uma forma que facilita a infecção das vias urinárias né Principalmente da mulher tá então é um patógeno pensando na questão do trato urinário é que normalmente que é o mais frequente isolado em amostras de urina no caso da urocultura e patógenos menos frequentes com relação a infecções do trato urinário e enterobacter clipse ela Proteus e pseudomonas nós temos aqui outros exemplos de gêneros
que também podem causar infecções do trato urinário mas que com menor frequência Não não é normalmente não é comumente isolado como no caso do gênero e escrita tá E aí eu coloquei aqui um detalhe né É linhagens enterotoxigênicas tá de esqueriquiacoli a o gênero a espécie cole apresenta em cima da mente 200 sorotipos diferentes que falar sobre isso em uma aula específica querer falar apenas da da espécie cole da escherichia Coli e entre esses 200 soro tipo de e cole aproximadamente que já foi identificado tem alguns que são entrou toxigênicos né ou seja são produtores
de toxinas né então linhagens enterotoxigênicas é descrita cole são uma causa comum de diarreia nos países em desenvolvimento né então países em desenvolvimento a é comum é as pessoas apresentaram apresentar em quadros de diarreia diarreia aquosa a por uma infecção e por linhagens enterotoxigênicas de esqueriquiacoli que aí eu vou falar com mais detalhe em uma aula específica sobre a esqueriquiacoli irei falar sobre todos todos esses sorotipos né é que fazem parte aí desses 200 sorotipos já foi identificado aqueles que são os mais importantes que são os mais patogênicos e os mais estudados tudo bem e
agora com relação aos mecanismos né de patogenicidade Então os bacilos gram-negativos de importância médica que são responsáveis por causar diarreia né que a diarreia é é um o sinal Clínico né de que alguma coisa de errado está acontecendo dentro do intestino do indivíduo e que ele apresenta o quadro de diarreia aquosa né fezes líquidas Então dependendo do gênero dependendo da bactéria do bacilo gram-negativo é que tá causando esse quadro de diarreia pode ser por mecanismos diferentes tá então eu destaquei aqui três mecanismos diferentes então a mediados por enterotoxina Ou seja você pode ter uma infecção
intestinal por algum bacilo gram-negativo Oi e aí tem corrente dessa infecção você Está apresentando um quadro de diarreia diarreia aquosa né ou seja uma diarreia é totalmente é só fezes né completamente líquidas tá ou seja uma quantidade de água muito muito grande então isso que ele que a cole né que você pode ter uma infecção intestinal por esqueriquiacoli é por linhagens enterotoxigênicas Como já citei anteriormente e que você irá apresentar um quadro de diarreia né tendo com o mecanismo responsável né Por esse Pablo de diarreia toxinas que a escrevi que a cola está produzindo lá
no intestino Então essas toxinas que são produzidas né chamadas de inter o toxinas Elas irão interferir na capacidade de absorção né pelos enterócitos assim como contribuindo para uma maior secreção bom para intestino fazendo com que a pessoa apresente aí essas fezes aquosas né temos também o vidro eu cobre né e o Cola inclusive aqui no canal eu já postei uma vídeo aula falando sobre o vídeo Cola e lá eu explico de forma bem detalhada o mecanismo de patogenicidade do vidro cole que é uma bactéria que causa um quadro de diarreia aquosa sério né uma é
grave que dependendo da idade pode até levar o devido a óbito por um quadro de desidratação intenso a mediado por entrou toxina você já toxinas que a bactéria produz lá no intestino que vai interferir né na capacidade é hidroeletrolítica né Ou seja no controle tanto de absorção quanto dia excreção de líquidos né no caso de água assim como de eletrodos tá e tem e aqueles bacilos gram-negativos que tem uma capacidade invasiva e inflamatória né quando eu falo assim uma capacidade de base inflamatória é que consegue invadir os enterócitos que são as principais células que constituem
a mucosa intestinal então além dessas bactérias conseguirem invadir os enterócitos também desencadeiam um processo inflamatório e aqui como exemplos temos salmonella Mais especificamente cursor o tipo de figurino né que a salmonella typhimurium x ela né a tigela dizem ter ir à espécie dysentery campylobacter jejuni e come linhagens enteropatogênicas assim como a escrita é come o 157 H7 que é um sorotipo inteiro hemorrágico então Aqui nós temos diferentes exemplos de bacilos gram-negativos que possui o anistas né é diferentes no caso aqui da escrita é Cole do vidro colei ou seja apresenta uma capacidade invasiva inflamatório invadem
os enterócitos e desencadeia um processo inflamatório diferente de uma bactéria que seja apenas enterotoxigênica né Ou seja que produz unicamente toxinas E essas toxinas não irão causar um dano a mucosa mas apenas irão interferir no funcionamento da célula já uma causa aqui neste segundo exemplo além de invadir a célula vai desencadear o processo inflamatório que pode causar um dano a mucosa intestinal tá e tem aquelas espécies que possuem mecanismos que também causam diarreia porém por mecanismos incertos como por exemplo vibrio parahaemolyticus e a yersina enterocolitica o teu vibrio parahaemolyticus algumas linhagens produzem em ter o
toxina então podem causar é um quadro de diarreia por produzirem entre o toxinas toxinas né porém o seu papel patogênico não é claro não está claro ainda né não é tão [Música] definido como por exemplo vive o colo tá e a yersina enterocolitica algumas linhagens produzem entrou toxina também Contudo não tenho um papel patogênico ainda muito definido muito esclarecido certo e a aqui nessa tabela nós temos Diferentes né gêneros assim como espécies de bacilos gram-negativos e são responsáveis por infecções do trato urinário ou sepse então preste atenção anteriormente eu falei com relação a gêneros e
espécies que causam diarreia o que é um quadro clínico intestinal né Ou seja é uma infecção intestinal interna agora eu vou falar aqui sobre infecções do trato urinário ou sepse ou seja são infecções também causadas por bacilos gram-negativos por enterobactérias ou seja espécies gêneros que fazem parte da família enterobacteriaceae se porém causam infecções extraintestinais infecções fora do intestino claro que uma mesma que causa uma infecção em e ela pode também causar uma infecção extra-intestinal já tem aquelas que causam unicamente infecções intestinais assim como também tem aquelas que causam infecções apenas extra-intestinal está no caso apenas
infecções do trato urinário por exemplo então aqui ó temos a isso que ele fica Cola então a esqueriquiacoli é um exemplo de bactéria que pode causar infecção tanto intestinal como extra-intestinal claro que com maior frequência infecção extra-intestinal no caso aí principal Exemplo né infecção de urina infecção do trato urinário que é o que nós tipo eu já citei numa aula anteriormente né no dos slides anteriores e enterobacter cloacae é um outro exemplo aqui de bactéria que pode causar infecções do trato urinário assim como causa infecções nosocomiais e frequentemente exige resistência a fármacos cliente se ela
pneumoniae apresenta a grande cápsula do Code Ou seja é uma bactéria em capsulada Eu já falei sobre isso né sobre as bactérias possuem cápsulas são bactérias é altamente resistentes porque a cápsula é um grande fator de virulência que tanto interfere no mecanismo de fagocitário como também a pensando na questão de tratamento na questão de antibióticos são bactérias mais protegidas né ou seja não é qualquer antibiótico vai conseguir passar através dessa cápsula então acaba só um grande fator de virulência e nós temos aqui um exemplo aqui ou se ela pneumonia Oi tá serratia marcescens estão a
serratia marcescens é uma outra um outro exemplo de bacilo gram-negativo responsável por infecção do trato urinário Proteus mirabilis e pseudomonas aeroginosa né a pseudomonas aeruginosa tanto pode causar infecções de urina como também pode causar outros tipos de infecções principalmente em lesões na pele como pós queimadura ou no caso de um ferimento de pele ou no caso decorrente de um processo cirúrgico na Então são bactérias que podem causar infecções tanto intestinais como exemplo esqueriquiacoli como extra intestinais e temos aquelas que causam infecções e exclusivamente é extra intestinais né o por exemplo Proteus mirabilis O que são
exemplos de bactérias que normalmente causa infecções aí fora do trato gastro intestinal tá então os pacientes infectados por patógenos entéricos ou seja por enterobactérias como por exemplo x ela salmonela campylobacter Sinhá né exibem alta incidência de determinadas doenças autoimunes com síndrome de Reiter Olha só Além de a pessoa ter todas as complicações né Como por exemplo o padrão de diarreia desinteria né ou com outras infecções né infecção de urina né o indivíduo apresenta um risco ainda de desenvolver uma doença auto-imune em decorrência dessa infecção primária né teve como qualquer uma dessas espécies desse gênero sair
é desse gêneros aqui que eu citei então a síndrome de Reiter conhecida também como artrite reativa é uma doença e o mágica com tendência a cronicidade né poxa Professor mais como que é por qual mecanismo né que eu tenho lá uma infecção uma shigelose uma salmonelose né que são infecções intestinais e eu desenvolvo depois uma doença auto-imune isso pode acontecer por uma reação cruzada né que ele chama de reação cruzada ou também conhecida como mimetismo molecular quando você tem uma infecção por uma determinada bactéria o seu sistema imunológico ele vai desencadear uma resposta né com
a produção de anticorpos assim como a produção de outros componentes do sistema imunológico contra aquele microorganismo é só que aí esse microrganismo ele pode conter antígenos né ontem você produziu anticorpos por exemplo contra esses artifícios que são atingidos muito semelhantes antes os próprios que podem estar nos seus tecidos nas suas células e tem um determinado momento né a esses anticorpos esses componentes do sistema imunológico eles podem passar a identificar esses antígenos próprios por serem muito semelhantes a esses antígenos bacterianos e assim não tem capacidade de diferenciar se é um atingir uma criado ou não E
aí desenvolve uma reação inflamatória né nesse local onde haverá e esse reconhecimento através dos componentes do sistema imunológico Tá além disso infecção por campylobacter jejuni inclusive aqui no que eu falei sobre essa espécie predispõe a síndrome de guillain-barré Ea síndrome de guillain-barré também é uma doença de caráter auto-imune ela é marcada pela perda né da bainha de mielina que é um revestimento que nós temos os nossos axônios é dos neurônios e dos reflexos tendinosos é fraqueza muscular progressiva acidente é o principal sintoma da síndrome de guillain-barré ou seja o indivíduo ele vai apresentando uma fraqueza
muscular é periférica por uma degradação da bainha de mielina dos nervos periféricos que inervam essa musculatura perdendo assim a força né o tônus muscular por uma a por matar que vamos dizer assim através de componentes do próprio sistema imunológico e não tem corrente uma reação autoimune né é depois que o indivíduo ele apresentou uma infecção por campylobacter jejuni ou pode ser até durante a infecção por campylobacter jejuni tá bom então com relação a patogênese e aqui de modo geral né todos os membros da família enterobacteriaceae por serem gram-negativos e se algo que eu já discuti
nas aulas básicas da microbiologia lá na parte da nas aulas que eu falei sobre todas as estruturas que uma bactéria possui com as bactérias as bactérias e foram negativas Diferentemente das bactérias gram-positivas elas possuem uma membrana externa né além da membrana citoplasmática elas possuem uma segunda membrana externa e na superfície dessa membrana externa né que é comum apenas nas bactérias gram-negativas a contém endotoxinas que é o famoso lipídio a né A além disso essas bactérias além de conter e né e do Tom o vídeo aqui ele pediu aqui ele faz parte de uma estrutura conhecida
como LPS né que eu limpo polissacarídeo à base de sílica polissacarídeo que está Avenida que está presa a membrana externa das bactérias gram-negativas é o lipídio a né que é o componente altamente tóxico né antigênico que é responsável pelos sinais clínicos de uma infecção por um bacilo gram-negativo né então por exemplo aqui ó a esqueriquiacoli ou vibrocore secreto quando eu tive dele tem uma infecção é portanto por e cole contra o vídeo a independente do local onde esteja acontecendo essa infecção essas bactérias né esses bacilos gram-negativos eles secreto exotoxinas né denominadas de enterotoxinas caso essa
e eu tô conseguindo ver mas estejam sendo produzidas lá no intestino me chama de entrou toxinas onde essas Inter o toxinas elas activo adenilato ciclase no interior das células intestinais no caso dos enterócitos como as podemos ver aqui né Então essas entrou toxinas elas conseguem ativar a adenilato ciclase né Por uma ativação da proteína G que está presente na face interna da membrana citoplasmática interna dos enterócitos ativando assim adenilato ciclase e com essa ativação da guanilato ciclase haverá né uma desregulação do mecanismo hidroeletrolítico nas células intestinais provocando um quadro de diarreia aquosa a professora não
entendi muito bem isso assista a aula que eu falei o vibrocore que aí você vai entender né de forma bem detalhada esse mecanismo tudo aqui né de ativação da proteína C da adenilato ciclase né até a secreção de íons como de cloro sódio e água causando assim responsáveis provocando É melhor um quadro de diarreia aquosa tá então as os bacilos gram-negativos é responsáveis por causar quadros de diarreia né quando é esse quadro de diarreia ele acontece por a produção né recorrente da produção de exotoxinas se dá por esse mecanismo aqui a é importante lembrar quando
eu falei lá atrás de outros mecanismos que pode acontecer tem a questão de algumas BA a tirinha capacidade invasiva né só que aí já é diferente aí Então nesse caso a bactéria vai conseguir entrar dentro do Inter ócito ela vai destruir o inter ou assisto ela vai causar um processo inflamatório nesse caso aqui não se tem a destruição do Inter nosso não se tem um processo inflamatório porque o que está causando tudo isso daqui é a entrou toxina né que a bactéria que está presente ali na superfície dos enterócitos está secretando tá com outro ponto
importante com relação aos bacilos gram-negativos é que essas bactérias elas possuem antígenos né E esses antígenos eles são e é importante Primeiramente você saber quais são né ah e para quê que esses antígenos servem como por exemplo salmonella e shigella né ele aqui dois exemplos salmonella e e são exemplos de gêneros que possuem espécies a que possui esses antigos assim como outros gêneros também não e esses antígenos eles são importantes principalmente para a identificação né no laboratório clínico com também em caso de Investigações epidemiológicos né o objetivo de identificar é especificamente Qual é o sorotipo
é que está causando aquele surto de diarreia aquele surto né de infecção intestinal e quais são esses antígenos que podem estar presentes nos máximos gram-negativos Lembrando que a São três né esses que eu estou destacando aqui necessariamente a bactéria ela não precisa ter uns três ela pode ter apenas um corpo pode ter dois pela pode ter os 3 tá então o emitido ó também conhecido como antígeno somático é uma tijolo que está pra a parede celular na parede da célula bacteriana Mais especificamente da superfície né a da membrana externa que corresponde a parte externa do
lipopolissacarídeo é Olimpo polissacarídeo que a composto lá pelo lipídio a e por vários açucares então lá na extremidade né tô aqui tá a membrana externa teu like lá e aqui estão os vários açucares que formam aquela estrutura chamada de LPS então aqui na extremidade do LPS né Nós temos o antígeno o Né o antes e o watchista somático que corresponde essa parte externa do lipopolissacarídeo sabe então que isso significa que as bactérias gram-negativas todos os bacilos gram-negativos possuem ulps então quem possui esse atingindo ó lá na parte externa né do LPS o antígeno h é
um antígeno flagelar ou seja está presente novo flagelo encontra-se na proteína flagelado é uma proteína que está presente né lá na composição do flagelo então que isso significa apenas em organismos flagelados como por exemplo Skin rica e salmonella é possível identificar o antígeno h Então aquela bactéria que não é fla gelada que não possui flagelo né ela não possui esse antígeno h e o antígeno cá o antígeno Car é um antígeno polissacarídeo capsular esse antígeno cá né o antígeno polissacarídeo capsular está presente apenas em bactérias que possuem cápsula né então a cápsula eu já discuti
isso as aulas com vocês é um fator de virulência é uma estrutura facultativa né uma estrutura não essencial e que algumas bactérias possuem outras não Então aquela bactéria que possui cápsula ela contém esse antígeno cá né que a batismo polissacarídico capsular que está presente na cápsula polissacarídica então apenas as bactérias que possuem cápsula polissacarídica é contém esse a Tijuca né então através desses antígenos é possível identificar fazer a identificação né no laboratório clínico para identificação de determinados objetivos que esteja causando uma infecção caso o médico ele solicite né saber qual é o seu tipo específico
ou no caso de Investigações epidemiológicos para terminar um determinado sobre o tipo responsável por algum surto de diarreia e algum surto né de e são intra ou extra intestinal causado por algum tipo de bacilo gram-negativo o diagnóstico Laboratorial né como que é realizado o diagnóstico Laboratorial é desses membros né das em tudo da família enterobacteriaceae né dos bacilos gram-negativos então existem pensando aí a em meios de Cultura então uma amostra biológica uma mostra como é com suspeita de ali naquela mostra como ter algum tipo de bacilos gram-negativos a gente pode utilizar uma placa de Agar
sangue né e um meio seletivo e diferencial quando eu me refiro ao meio seletivo diferencial que eu posso citar aqui dois grandes exemplos né que meios que são indispensáveis quem que a gente tem que sempre utilizá-los né não necessariamente os dois mais pelo menos um dos dois para um cultivo né para cultivar é um bacilo gram-negativo que possa estar presente ainda tentado o material biológico além do Agar sangue que é um outro meio que ele não é seletivo diferencial o meio água sangue ele é unicamente diferencial tá então a esses dois exemplos de meio seletivo
diferencial um é o Álvaro marcou o quê e o outro é o argan e Usina azul de metileno o famoso e MB o que que esses dois meios aqueles são indispensáveis que a gente sempre tem que utilizar para o cultivo né de uma determinada amostra biológica que se tem uma suspeita de infecção por algum bacilo gram-negativo é que esses meios eles tem essa característica que eu já citei anteriormente de ser seletivo diferencial eles têm a capacidade de isolar ou seja denny bactérias gram-positivas permitindo o crescimento de bacilos gram-negativos então isso já é um se você
já é uma grande vantagem tô quando você observa o crescimento no HMB ou crescimento no Agar macconkey Então você já consegue né é fake ali né Possivelmente seja um bacilo gram-negativo é por essa característica seletiva que esses meios apresentam e a questão diferencial essa questão diferencial está relacionado a identificação desse bacilo gram-negativo dele ser fermentador e lactose e não fermentadores de lactose que é o que eu já falei lá no comecinho nas características gerais né então aqui eu coloquei os dois meios o agora uma com quem o e o aviãozinho azul de metileno no caso
agora macuque vocês já devem saber Identificar qual bacilo gram-negativo ele é lactose ou seja fermentador de lactose ou não é de lactose então todos aqueles que apresentar em né colônias com uma coloração Rosada né um rosa claro e rosa escuro ou colônias avermelhadas são né Isso significa que é um bacilo fermentador de lactose e aí nós podemos destacar aqui esqueriquia clique se ela entrou galactico ser rápido agora não abra uma com que quando essas colônias elas adquirem uma coloração incolor né ou estressadas e você pode Além disso observa alguma tonalidade amarela do Agar macconkey que
ele tem Originalmente uma cor Rosada ele muda de cor de ficar Amarelo então isso já caracteriza que é uma bactéria que não é fermentadoras de lactose que a famosa lactose negativa que aí você já pode desconfiar de uma tigela de nossa algo nela para o Deus Providência organela e yersinia ou um abraço aí no agora eu Usina azul de metileno o a Gabrielzinho azul de metileno ele e ele também é um meio seletivo e diferencial ele também tem a função de selecionar o crescimento de bacilos gram-negativos e também permite aí a diferenciação né entre uma
fermentadoras de lactose de uma não fermentadoras de lactose então aqui eu coloquei três exemplos eu tenho aqui três exemplos né de bactérias a que foram cultivadas no HQ MB Então nesse primeiro exemplo aqui nós podemos observar aqui no HMB que foi realizado o cultivo de e cole e quais são as características que são identificadas no HMB quando você faz a cultivo de Record as colônias elas crescem esse meio primeiro se houve o crescimento então isso já te dar um direcionamento que trata-se e gram-negativo E aí você observa essas colônias pretas então isso já é uma
característica aqui a e cole tem né não abre a e b apresentam colônias pretas né colônias escuras E além disso Quê que a gente observa a gente observa aqui onde houve o crescimento né dessas colônias pretas e escuras a presença de uma tonalidade né que a gente chama de verde metalizado né Se você pegar o meio e mexer e assim né É na luz você consegue ver aí um verde metalizado Então isso é característico de disso queria que a colo tá Jaru nesse segundo exemplo aqui nós temos a credencial a pneumonia a crise ela pneumoniae
é também um bacilo gram-negativo quando esse essa bactéria é cultivada no HMB ela e fica colunas azuis Então essas colônias azuis isso é característico de uma bactéria de um bacilo gram-negativo por ter crescido no HMB e quando tem essa tonalidade azul né é característico de uma bactéria lactose positiva né então Aqui nós temos e como é lactose positiva crebiciela pneumonic lactose positivo e quando a bactéria ela é lactose negativa no hnb vai apresentar por exemplo aqui salmonella enteritidis né o gênero salmonella todas as espécies que pertence a esse gênero são lactose negativas estão aqui nós
observamos colônias que são incolores né coronhas aí que parecem é gotas de água que né na super presente na e esse meio que é a mesma característica quando cresce no abra MP no Agar macconkey perdão colônias com essa característica com esse aspecto incolor tá então esses dois meios aqueles são indispensáveis sendo que o Álvaro marcou que é um dos meios que a gente mais utiliza no laboratório de microbiologia né tanto realização de urocultura né para o cultivo de urina de pesquisar bactérias é em urina que possa estar causando infecção de urina assim como também no
caso a pesquisa de microrganismos de bactéria e material fecal assim como em outros materiais biológicos tá o HMB também é muito solicitado muito utilizado assim como em outros meios de Cultura também é destinados ao a cultivo né desses microrganismos com hsse assim é outros exemplos Tá certo e com relação à terapia antibiótica né então a infecções causadas por bacilos gram-negativos né causadas por enterobactérias para algum membro desta família enterobacteriaceae se a são tratados com antimicrobianos né então uma ampla Gama de Agentes antimicrobianos a é potencialmente efetivos né como por exemplo penicilinas cefalosporinas aminoglicosídios cloranfenicol tetraciclinas
E quinolonas sulfonamidas então Aqui nós temos diferentes tipos de antibióticos que são altamente potencialmente efetivos contra na esses diferentes representantes diferentes espécies de bacilos gram-negativos Só que tem um detalhe muito importante é o ideal é que sempre antes da prescrição O que é um desses antibióticos seja realizado né claro você precisa primeiro Identificar qual é o microrganismo qualquer espécie né Qual é o gênio ele qualquer espécie realizar o antibiograma primeiramente né tô aqui no no canal eu mas para frente eu irei né postar uma aula mostrando o passo a passo como que realizado o antibiograma
Para que serve o antibiograma né então Só adiantando antibiograma é um exame e que ele é realizado exatamente para identificar qual antibiótico que pode ser utilizado né qual antibiótico é sensível com antibiótico que a existente Para uma determinada bactéria que tá causando uma infecção no paciente agora porque que recomenda-se que primeiramente faça um antibiograma para saber qual é o antibiótico muitos isolados de bactérias entéricas ou seja de bacilos gram-negativos São altamente resistentes e a antibióticos né devido a capacidade dessas bactérias é ter a capacidade de produzir de produção de beta-lactamases beta-lactamases é uma enzima né
em que essa enzima ela tem a capacidade de degradar de multi modificar a estrutura química de certos antibióticos como por exemplo os betalactâmicos com por exemplo as penicilinas assim como pode produzir outras enzimas que podem também modificar a estrutura farmacológica de outros fármacos Então por essa característica que algumas né por essa capacidade né de produzir essas enzimas que alguns bacilos gram-negativos tem eh recomenda-se que seja feito um antibiograma para ter certeza né qual antibiótico certo deve ser prescrito para aquele paciente né além é né além dessa capacidade dessas bactérias algumas produzirem essas enzimas a esses
organismos né frequentemente realizam conjugação A conjugação Eu já falei sobre isso conjugação transdução transformação que são mecanismos é que algumas bactérias realizam é que consegue transferir material genético de uma para outra né e assim conferindo resistência né então alguns bacilos gram-negativos frequentemente realizam conjugação adquirindo plasmídeos é plasmídeo R que são plasmídeos que possuem genes que medeiam a resistência a múltiplos fármacos então nós podemos ver aqui duas formas diferentes com as bactérias elas podem adquirir resistência a antibióticos por ter uma capacidade de produzir enzimas naturalmente enzimas que a ficar fármacos web assim ela se tornar resistente
e se fala com também pela capacidade que elas têm de estar realizando a conjugação transferir transferindo plasmídeo R que são plasmídeos que contém genes né que codificam que permitem águia a síntese de substâncias que a acaba conferindo a esse microrganismo resistência a múltiplos fármacos ou seja para vários tipos de fármacos então nós podemos ver aqui entender a importância de se realizar o antibiograma antes né É ou seja logo após a identificação do gênero e da espécie então seguindo essa conduta você vai aí é diminuir os riscos né de a escrever um antibiótico o paciente e
Não surtiu um efeito né então solicitando o antibiograma ou seja vai ter certeza do que para escrever e assim realize ter neve no tratamento efetivo gente então é essa como eu falei foi a primeira é a primeira aula sobre os bacilos gram-negativos é uma aula introdutória é eu acho que no meu ponto de vista que tem várias informações que são extremamente importantes e claro eu irei eu já tenho algumas aulas assim como eu vou postar várias outras em que eu vou estar falando especificamente é de determinadas espécies e gêneros é de bacilos gram-negativos tão Desejo
a todos vocês aí é bom estudo que eu possa ter contribuído de alguma forma através dessa aula e não deixa e no canal e ativar o Sininho para receber as notificações eu vejo que muitos estão inscrito no canal é aqui é assistem as vídeo-aulas porém não estão inscritos no canal se inscreva no canal e ative na o senhor e assim vocês irão receber notificações sempre estarei postando uma vídeo aula então até breve até uma próxima aula
Related Videos

35:52
Microbiologia Médica: Shigella
CS Ciências da Saúde
9,924 views

56:38
Microbiologia Médica: Enterokit B - Identi...
CS Ciências da Saúde
5,918 views

17:59
Bactérias Gram Positivas e Gram Negativas ...
Dr. Akadêmico UFRGS
20,574 views

55:09
Família Enterobacteriaceae MED 2021
ALEXANDRE LOURENÇO
6,074 views

14:01
Como identificar bacilos gram negativos (f...
MicroClass do Marcelo Oliveira
3,804 views
1:20:02
Série Bioquímica de identificação para bac...
Canal do Residente Biomédico
6,395 views

31:50
Microbiologia Médica: Antibiograma
CS Ciências da Saúde
21,834 views

7:45
ESCHERICHIA COLI (E. COLI) - PROF. ALEXAND...
Alexandre Funck
79,160 views

1:02:26
Microbiologia Médica - Neisseria meningitidis
CS Ciências da Saúde
7,835 views

36:45
Microbiologia Médica: Listeria monocytogen...
CS Ciências da Saúde
6,311 views

17:11
Mecanismos de ação dos antimicrobianos e r...
Estágio em Clínica Pediátrica
17,344 views

2:08:31
Micro Vet 2016.1 Aula #06 e 07 - Enterobac...
Prof. Danilo Stipp
5,439 views

27:13
Microbiologia Médica: Clostridium difficil...
CS Ciências da Saúde
7,261 views

58:21
Quais assuntos mais cobrados em Microbiolo...
Gran Cursos Saúde
15,895 views

34:53
11) Ágar MacConkey | Meio de Cultura Selet...
IBAP Cursos
13,029 views

49:57
Microbiologia Médica: Mycobacterium tuberc...
CS Ciências da Saúde
18,142 views

5:13
PERDI 15kgs!? O QUE ACONTECEU COMIGO?
Paulo Muzy
5,615 views

1:39:55
Micro Vet 2015.1 Aula #14 - Enterobactérias
Prof. Danilo Stipp
5,777 views

37:47
Microbiologia - Bactérias
CCBS
91,366 views

42:43
REINO MONERA - BACTÉRIAS - Aula | Biologi...
Biologia com Samuel Cunha
932,453 views